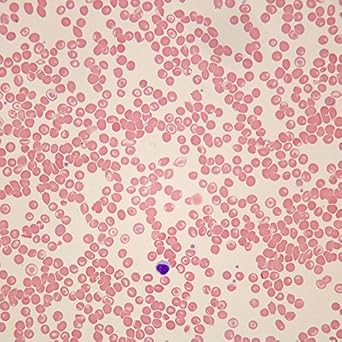

Home ⇨ Blood cells under microscope 40x
Blood Cells Under Microscope 40x
Get Blood cells under microscope 40x Free HD - Check out this fantastic collection of Best HD wallpapers, with the Best HD background images for your desktop, phone or tablet. Today i will share Blood cells under microscope 40x wallpaper. If paint simply is not cutting it, you can add patterns and detailing to the walls of your home with wallpaper.

Get Blood cells under microscope 40x Free